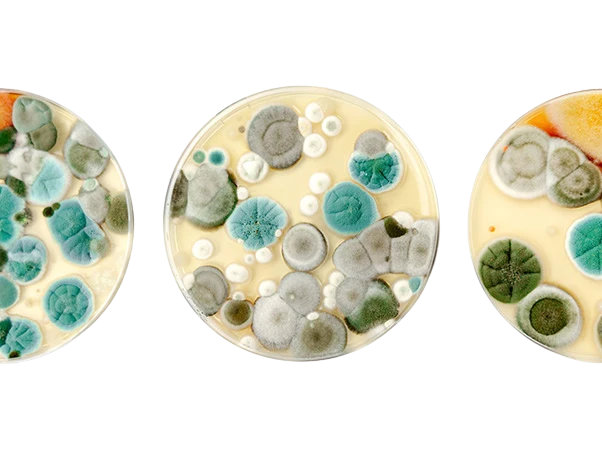

Sobre nós
Conheça a BIOINPUT
Somos uma empresa de biotecnologia fundada em janeiro de 2020, com a missão de revolucionar a agricultura por meio da inovação verde. Nosso propósito é fornecer biossoluções que atendam às crescentes demandas da agricultura sustentável e regenerativa, contribuindo para um impacto positivo tanto no meio ambiente quanto na sociedade.
Nosso diferencial está no desenvolvimento de tecnologias biológicas disruptivas e personalizadas. Para isso, contamos com uma equipe multidisciplinar de pesquisadores altamente qualificados, que trabalham em todas as etapas do processo, desde a concepção até a entrega do produto biológico.
Bioprospecção de Microrganismos Exclusivos
Isolamos microrganismos com grande potencial biotecnológico para uso na agricultura, garantindo soluções personalizadas para cada projeto.
Possuímos + 2000 cepas no nosso banco de biossoluções.
Bioprocessos Avançados
Na BIOINPUT, otimizamos o bioprocesso para potencializar a genética dos microrganismos, garantindo produtos altamente eficazes para a agricultura.



Formulação Inovadora
Desenvolvemos tecnologias de formulação inovadoras que protegem os microrganismos e garantem sua entrega precisa e eficaz, maximizando os resultados em campo.
Nossa Missão
Promover a sustentabilidade agrícola por meio da pesquisa e inovação.
Nossa Visão
Ser referência no setor de soluções biológicas para a agricultura
Nossos Valores
Buscamos um futuro equilibrado por meio da inovação e sustentabilidade, priorizando qualidade, integridade e colaboração. Com comprometimento e respeito ao meio ambiente, construímos um legado transformador.
Bioprospecção de novos agentes de biocontrole
Consórcios microbianos
Otimização nos bioprocessos e formulação
Pesticidas Nanobio


